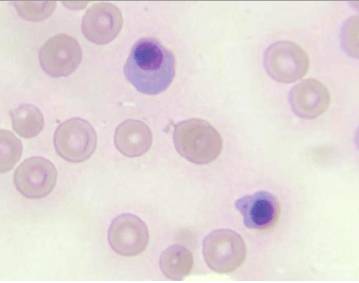
Эритропения

Содержание
Эритроциты – это красные кровяные тельца, чья функция осуществлять транспорт полезных веществ и кислорода ко всем клеткам и тканям, забирая шлаки и токсины, а также углекислый газ. Они принимают участие в межклеточном обмене, поддерживают щелочной баланс крови, участвуют в иммунных реакциях, а также свидетельствуют о состоянии здоровья в целом. Их уровень, который способен меняться с возрастом, может говорить о нормах или отклонениях, что связывают с наличие проблем со здоровьем. Какова норма этого показателя у детей, как меняются показатели с возрастом и от каких параметров зависят, узнаем далее.
Нормальный уровень у детей: особенности
Почему так важно, чтобы уровень этих красных кровяных телец был в пределах нормы? Все просто. Дело в том, что эритроциты способны выполнять множество жизненно важных функций, но главенствующей остается транспорт кислорода. Именно без этого вещества жизнь и полноценное функционирование организма невозможно.
Отклонения в показателях эритроцитов свидетельствует в первую очередь о том, что организм недополучает важных микроэлементов и кислорода, на фоне чего развиваются патологические состояния, перерастающие в серьезные заболевания.

Также существуют показания, которые служат поводом к исследованию эритроцитов. Сюда относят:
- плохой набор веса у новорожденных и детей дошкольного возраста;
- частые респираторные заболевания (с периодичностью более 1-2 раза в месяц);
- слабость и постоянная усталость ребенка;
- отсутствие аппетита.
Контроль эритроцитов производится в ходе лечения какого-либо заболевания, по результатам анализов которых можно определить эффективность терапии.
Особой подготовки к забору крови не производится. Для более достоверных результатов необходимо сдавать кровь натощак в первой половине дня.
Врачи подчеркивают важность контроля уровня эритроцитов в крови у детей, так как это может служить индикатором общего состояния здоровья. Нормальные значения варьируются в зависимости от возраста и пола ребенка. Например, у новорожденных уровень эритроцитов может быть выше, чем у детей старшего возраста, что связано с адаптацией организма к новым условиям жизни. Специалисты отмечают, что как низкий, так и высокий уровень эритроцитов может указывать на различные заболевания, включая анемию или полицитемию. Регулярные анализы крови позволяют своевременно выявлять отклонения и принимать необходимые меры. Врачи рекомендуют родителям обращать внимание на общее состояние ребенка и при наличии подозрений на проблемы со здоровьем обращаться за консультацией.

Показатели нормы
Следует понимать, что уровень эритроцитов у детей непостоянен и может изменяться в зависимости от возраста.
Это объясняется сложными биохимическими процессами, которые происходят в детском организме, формируя и адаптируя его к условиям жизни. Основные показатели нормы отображает представленная таблица.
| Возраст ребенка | Показатель нормы |
| у новорожденного (пуповинная кровь) | 3,9-5,5 |
| первая неделя жизни | 3,9-6,0 |
| вторая неделя жизни | 3,6-6,2 |
| 1-3 месяца | 2,7-5,4 |
| 3-6 месяцев | 2,9-4,0 |
| 6-12 месяцев | 3,1-4,5 |
| 1-3 года | 3,5-5,1 |
| 3-5 лет | 3,9-5,0 |
| 5-7 лет | 3,5-4,7 |
| 7-12 лет | 3,6-4,9 |
| 12-15 лет | 3,9-5,5 |
| 15-18 лет | 3,5-4,8 |
После 18 лет показатели нормы эритроцитов такие же, как и у взрослых – 3,6-5,6х.
В период активного роста и гормональной перестройки отмечается наиболее большой разброс в показателях нормы, что объясняется активным формированием подросткового организма.
Отклонения от нормы

Норма эритроцитов в крови у детей — важный показатель, который вызывает много обсуждений среди родителей и врачей. Многие родители беспокоятся о здоровье своих детей и стремятся понять, что означает уровень эритроцитов. Врачи объясняют, что нормальные значения могут варьироваться в зависимости от возраста и пола ребенка. Например, у новорожденных уровень эритроцитов обычно выше, чем у детей старшего возраста.
Некоторые родители отмечают, что низкий уровень эритроцитов может указывать на анемию, что требует внимания и возможного лечения. В то же время, высокий уровень может быть связан с обезвоживанием или другими состояниями. Важно помнить, что интерпретация результатов анализа должна проводиться квалифицированным специалистом, который учтет все факторы, включая общее состояние здоровья ребенка. Регулярные анализы крови помогают следить за изменениями и вовремя реагировать на возможные проблемы.

Эритроцитоз: причины и проявления
Эритроцитоз (эритремия) – довольно редкая патология, свидетельствующая о чрезмерной выработке эритроцитов в организме.

Физиологические – не связаны с наличием заболеваний, а возникают в результате негативного воздействия окружающих факторов. Сюда относят пассивное курение, когда ребенок становится заложником ситуации и вынужден вместо чистого воздуха вдыхать табачные дымы курящих родителей. Также интенсивно вырабатываются эритроциты в том случае, когда отмечается острая нехватка кислорода в организме: при сильных физических нагрузках или при длительном проживании в горной местности, лишенной полноценного кислорода.
Патологические – эти причины точно указывают на наличие заболеваний, причем различной этиологии:
- обезвоживание на фоне продолжительной рвоты и диареи;
- снижение функций коры надпочечников, что приводит к гормональному дисбалансу;
- врожденные пороки сердца;
- обструктивные заболевания органов дыхания;
- аномалии развития костного мозга, который производит эритроцитов больше, чем этого требуется для поддержания нормальной жизнедеятельности;
- сердечно-сосудистые заболевания (преимущественно полученные при внутриутробном развитии), выдающие себя характерной насыщенно красной окраской лица и шеи.
Наиболее опасная патология, для которой характерен неконтролируемый синтез эритроцитов – это рак костного мозга. Лечить его в большинстве случаев бесполезно, поскольку его первопричиной являются множество условных факторов, среди которых гормональный дисбаланс, аутоиммунные расстройства и другие.
Диагноз эритроцитоз устанавливается не только по количественному фактору, но и по качественному показателю.
В норме эритроциты все приблизительно одинакового размера, плотности и консистенции. Если имеется большое расхождение в размерах кровяных телец – это еще одно подтверждение наличия патологии.
Эритроцитоз может быть двух стадий:
Относительный – спровоцирован одним или несколькими факторами, устранив которые можно добиться нормализации эритропоэза без медикаментозной терапии.
Абсолютный – не поддается медикаментозной коррекции, полностью зависит от нарушений функций костного мозга.
Подобный диагноз длительное время не имеет никаких внешних проявлений, а о патологических расхождениях с установленными нормами родители ребенка, как правило, узнают случайно при плановом прохождении медосмотра.
Степень проявления того или иного типа эритроцитоза напрямую зависит от уровня отклонения от нормы, а также первопричины. Наиболее распространенными признаками патологии являются такие симптомы, как:
- артериальная гипертензия с присоединенной тахикардией;
- увеличение селезенки;
- кожный зуд без видимых на то причин;
- гипоксия тканей и приобретение синюшного оттенка, особенно конечностей;
- слабость, утомляемость плохой аппетит, беспокойный сон.
Как видим, симптомы могут указывать на множество других заболеваний, поэтому единственным способом предупредить развитие патологии – это лабораторный контроль анализа крови, который в детском возрасте лучше проводить не реже 1 раза в полугодие.
Эритропения: симптомы и причины возникновения
Эта патология имеет более конкретные проявления, сигнализирующие о проблемах с кроветворительной функцией.
Причины, которые послужили развитию патологического состояния, являются:
Обильные кровопотери, особенно при частых хирургических вмешательствах, при которых кровь не успевает синтезироваться.
Анемия, особенно железодефицитная, которая развивается на фоне неправильного питания, лишенного витаминов и микроэлементов, а также острый дефицит витаминов группы В и фолиевой кислоты.
Патологический гемолиз – процесс, при котором эритроциты быстро распадаются в общем составе крови и утилизируются организмом раньше, чем были выполнены их функции. Возникает этот процесс в результате гормонального сбоя или аутоиммунных расстройств, которые непосредственно влияют на костный мозг, внося в его функционирование патологические коррективы.
Задержка жидкости, которая возникает при нарушениях функций почек.
Наследственные патологии, которые передаются новому организму в виде испорченного гена ДНК, который несет в себе неверную информацию о функционировании кровеносной системы.
Наиболее опасной и малоизученной причиной является гемолиз при рождении, когда у матери вырабатываются особенные антитела к эритроцитам, которые передаются новорожденному через плаценту или грудное молоко.
Проявляется эритропения следующим образом:
- кожные покровы имеют белесый или желтый оттенок, присутствует пигментация;
- головная боль, тревожность ребенка, плохой сон;
- снижение артериального давления;
- частота сердечных сокращений падает.

Дефицит витаминов группы В и фолиевой кислоты.
Онкологические заболевания костного мозга или других органов с метастазами в костный мозг.
Врожденные патологии кровеносной системы.
В большинстве случаев малокровие вызывается неправильным питанием, малоподвижным образом жизни и генетической предрасположенностью. Лишь треть всех случаев возникновения патологии провоцируется серьезными болезнями.

Опасности данных состояний
И эритроцитоз и эритропения опасны по-своему и не должны оставаться без внимания.

Методы лечения
Единственный способ избавиться от дисбаланса эритроцитов в общей массе крови – это найти первопричину патологии.

- Коррекции питания – врач указывает на продукты, которые непосредственно влияют на эритроциты и их синтез, после чего обговаривается меню.
- Медикаментозной терапии – прием лекарств помогает избавиться от болезни, или сдерживать ее стремительное прогрессирование.
- Радикальные методы – переливание донорской крови или трансплантация клеток костного мозга помогают избавиться от проблем с кровью, причинами которых стали онкологические заболевания.
В 95% случаев диагностирования отклонений эритроцитов в детском возрасте, врач просит пересдать анализ крови повторно. Вероятно, если нет сопутствующих симптомов, ребенок здоров, а неудовлетворительные результаты – это следствие неправильного проведения анализа или забора крови.
В случае подтверждения подозрений, ребенка госпитализируют, после чего созывается консилиум, на котором строиться пошаговый план действий относительно дальнейшего обследования и лечения.
Профилактика
До сегодняшнего дня достоверно неизвестно, какая именно причина главенствующая и определяющая в развитии патологий эритроцитов. В связи с этим можно выделить всего три пункта, которые способствуют профилактике:
- Рационально питаться, избегая красителей и консервантов, а также фаст-фуда.
- Поддерживать баланс витаминов группы В и фолиевой кислоты, недостаток которых провоцирует анемию.
- Больше бывать на свежем воздухе: спортивные игры, активный отдых.
Эти три составляющие можно считать методами профилактики, однако даже они не гарантируют отсутствие проблем с кроветворением. Единственным способом не допустить развитие опасных для жизни болезней – это ранняя диагностика. Своевременное прохождение медицинских осмотров у детей помогает снизить риски развития онкологических заболеваний.
Таким образом, показатели уровня эритроцитов в детском возрасте имеют свои особенности и некоторые отличия, которые диктуются сложными физическими процессами, происходящими в незрелом организме. Важно контролировать уровень эритроцитов, поскольку незначительные отклонения могут свидетельствовать о наличии проблем со здоровьем. Поскольку внешне отклонения могут не иметь никаких проявлений, единственным способом контроля является лабораторное исследование крови из пальца.
Для оценки общего состояния эритроцитов во внимание берут не только их размеры и количество в общей массе крови, но и оценивают их функции (скорость оседания), благодаря чему получают полное заключение о состоянии здоровья ребенка.
Вопрос-ответ
Какова норма эритроцитов в крови у детей разных возрастных групп?
Норма эритроцитов варьируется в зависимости от возраста ребенка. У новорожденных она составляет примерно 4,1-6,1 миллиона клеток на микролитр крови, у детей до 1 года — 3,9-5,5 миллиона, а у детей старше 1 года — 4,0-5,5 миллиона клеток на микролитр.
Какие факторы могут влиять на уровень эритроцитов у детей?
Уровень эритроцитов может изменяться под воздействием различных факторов, таких как питание, наличие заболеваний (например, анемии), физическая активность, а также высота над уровнем моря, где проживает ребенок.
Каковы симптомы низкого уровня эритроцитов у детей?
Низкий уровень эритроцитов может проявляться такими симптомами, как усталость, бледность кожи, одышка, головокружение и учащенное сердцебиение. Важно обратиться к врачу для диагностики и лечения в случае появления этих признаков.
Советы
СОВЕТ №1
Регулярно проходите медицинские осмотры для вашего ребенка, чтобы контролировать уровень эритроцитов. Это поможет выявить возможные отклонения на ранних стадиях и своевременно принять меры.
СОВЕТ №2
Обратите внимание на питание вашего ребенка. Убедитесь, что в его рационе достаточно продуктов, богатых железом, витаминами B12 и фолиевой кислотой, которые способствуют образованию эритроцитов.
СОВЕТ №3
Следите за состоянием здоровья ребенка. Если вы заметили такие симптомы, как усталость, бледность или частые головокружения, обратитесь к врачу для проверки уровня эритроцитов и общего состояния крови.










